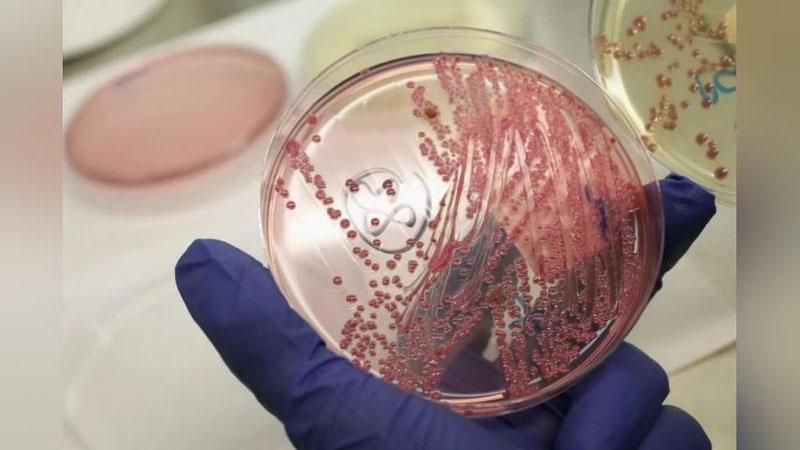

Санитария-эпидемиологик осойишталик ва жамоат саломатлиги хизмати вилоят бошқарма бошлиғи ўринбосари Жамшид Султонов бунга изоҳ берди.
Маълум қилинишича, вилоятда ҳақиқатдан ҳам куйдирги билан касалланган бемор аниқланган. Беморнинг яшаш жойи Сирдарё вилояти Сардоба туманида бўлган. Хасталик унга касалланган молни сўйиши ва унинг гўшт маҳсулотини истеъмолидан юққанлиги аниқланган.
Мутахассиснинг таъкидлашича ҳозирда бемор тузалиб, шифохонадан чиқарилган.
Маълумот учун: Бу касаллик ўткир юқумли бўлиб, у ҳайвонлардан одамга ўтиши мумкин. Хасталик халқ орасида Сибир яраси, “Илоҳий олов”, “Эрон алангаси” деб ҳам юритилади. Ушбу оғир дарднинг беморларда тери, ўпка ва ичак шакллари учрайди.
Ўз вақтида даволаш чоралари кўрилса хасталикнинг тузалиб кетадиган ҳамда энг кўп учрайдиган шакли – терининг очиқ жойларида учрайдиган тери яраларидир. Улар 95-99 фоиз, ўпка ва ичак шакли эса 1-5 фоиз учрайди.
Касалликни чорва билан шуғулланувчилар, гўшт маҳсулотларини қайта ишловчилар, овчилар юқтириш эҳтимоли кўпроқ. Касал чорва гўштига етарли ишлов берилмаганда ва гигиена қоидалари бузилганда ҳам хасталик юқиши мумкин.